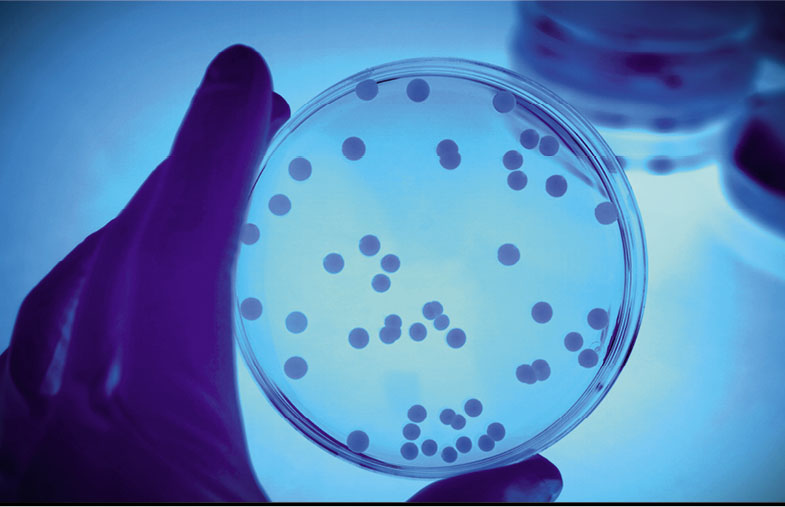
00.jpg

生物殺菌劑產品法規的三年發展情況
殺菌劑產品法規(BPR)自2013年9月1日開始生效,對在歐洲范圍內生產和使用殺菌劑實施規范。人們希望BPR能夠在協調歐洲內部市場的道路上走得更遠,實現過去發布的殺菌劑指令沒有達到的目標。
殺菌劑產品法規528/2012(BPR)的最初實施階段比較混亂,甚至在許多重要的實施細則仍需要制定時,最終的版本還尚未起草完成。僅3年后,進展情況如下:已經解決了一些不確定性,一些主要的法規條款也已制定頒布,但同時也出現了新問題。
BPR取代了1998年的指令,成為繼REACH和CLP之后又一重要的歐洲法規。與EU指令不同,EU法規對所有歐盟成員國都具有平等和直接的約束力。

委員會時間框架:現有活性物質監管品準106212014,AnnexⅢ

批準有關活性物質的決定(共758個活性物質檔案,審查了209個)(按照歐盟供應商名單進行審查,截至時間:2016年8月)。
該法規不完善嗎?
目前,令人感到意外的是BPR對于一些重要的戰略問題似乎只提供了一個粗略的框架。雖然手忙腳亂地工作了多年,起草了一些必要的細則和實施法規,但至今為止,大多數實施BPR的具體法令和指南仍有待落實(例如,對申請授權的數據要求進行考核與評估的指南)。實施BPR法規還需要有40多項參考文件,這些均尚未確定,這說明需要花費大量的人力和時間才能完成。盡管如此,受影響的公司仍需遵循各項法律的要求。
現有活性物質的評審計劃
與之前的指令一樣,BPR規定了殺菌劑產品上市銷售之前在歐盟和本國需要辦理的繁瑣的授權批準程序及產品授權程序。現有活性物質評審計劃的期限已經延期多次,因此備受爭議。現在,根據該法規所處的狀態以及ECHA的協調,似乎最新截止期限為2024年。對殺菌劑產品的制造商來說,要實施這一法規,他們必需要密切關注其產品的過渡期,以便可以迅速應對授權批準政策,否則就會被淘汰出局。
費用
殺菌劑產品的授權批準程序與藥品法和植物保護法規定的相似。值得注意的一點是,在過去的三年里,授權費增長迅速,這是在高額的文件編制費用上又額外添加的費用。在一些成員國中,一種殺菌劑產品的最終授權費可能與編制實際的授權批準申請費用一樣高。在一個成員國中評估一種殺菌劑產品的授權批準費用高達500000歐元。通常,在油漆和表面涂料行業中,受影響的公司都是一些中小企業,一般都缺乏熟悉處理授權批準事務的法務部門。另外,考慮到授權批準費用是基于實際的產品而不是其數量,所以應仔細權衡為獲得授權而作出的付出和成本與收益之間的平衡。
殺菌劑產品系列
殺菌劑產品系列是BPR的重大創新,并且尤其會對防護涂料和消毒劑產生影響。BPF是一組在規定變化范圍內(包括活性物質濃度的降低以及顏料、芳香劑和產品類型的變化)具有相似性能和相同活性物質的產品。現在已在一定程度上解除了最初對如何實施這一理念的懷疑。由貿易協會和歐盟委員會組織的相關研討會以及協調組的相關工作會議中最終確定了CA1和Q&A文件,為受影響的公司提供了指導。如果實施得當,可以節省一大筆授權批準費用,因為一個系列內的所有產品僅需要一次授權批準過程即可。
95條款名單
BPR的另一個創新內容是95條款。該條款規定:如果殺菌劑活性組分的制造商和進口商希望在歐洲銷售產品,他們就必須列入活性物質供應商名單之中。現在,殺菌劑產品的配方設計師也許只能從名單中的供應商得到其產品成分。此外,當局也許會要求提供其他形式的證明。毫不意外,許多成員國已對此已經提出了各種要求。對于更復雜的供應鏈來說,隨之而出現的是對供應商的保密問題。因此,為了公平競爭起見,例如一個商人他不應承擔向客戶泄露其供應商名稱的責任,雖然客戶為了獲得官方認可需要這方面的信息。一旦供應鏈延伸至多國之間,這種情況會更加嚴重。通常,這也會影響配方設計師,因為他們是供應鏈中的最終環節。
展望
殺菌劑產品中有很大一部分是使用在涂料和表面涂裝行業。在頒布BPR之前,某些產品(例如防污劑和木材防腐劑)已經需要獲得授權批準,而其他產品(如罐內防腐劑、涂料防腐劑和建筑材料的穩定劑)在今后的幾年中才會受到大眾的關注。建議將會受影響的公司評估其殺菌劑產品在未來的收益能力。盡管將來會進一步制定出更詳細的法規,以簡化授權批準過程,但基本的要求和成本仍然十分高,可能會使許多殺菌劑產品因成本原因而退出市場。
CA-Nov14-Doc.5.8-Final.rev3-Implementing the new BPF concept.doc
CA-May15-Doc.4.6.a-Final-Updated SPC template for BPF.doc
CA-March15-Doc.4.7-Final-BPF and SBP applications.doc

